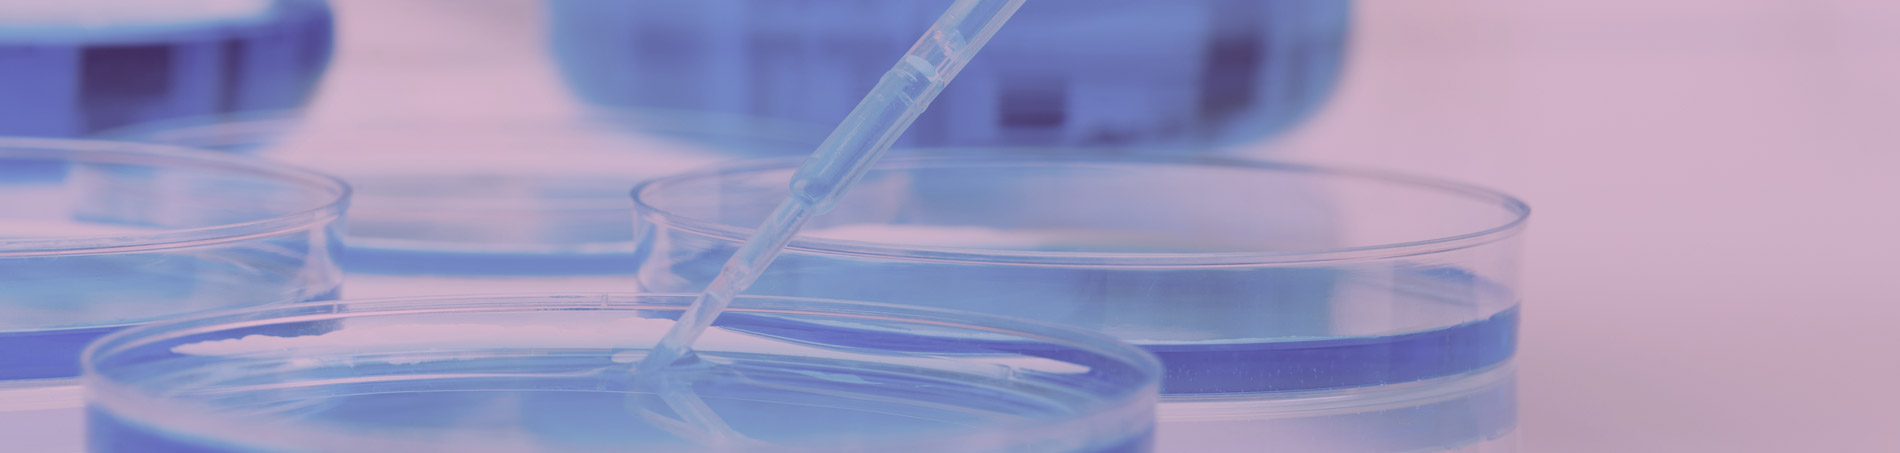

- Code: HS
- Certification: QQI Level 5 Award in Laboratory Techniques (5M3807)
- Duration: One Year
Description
This course will provide participants with a broad knowledge of the core sciences and an understanding of the Irish legal system. Participants will develop useful skills through hands-on laboratory work as well as an appreciation of the concepts particular to forensics. Students will also develop skills in problem solving, organisation, team work, effective communication and the use of technology. These skills are relevant to a wide variety of industries and professions including in An Garda Siochana, the Defence Forces, the State Laboratory and the Forensic Science Laboratory.
- Programme of Study
-
- Anatomy & Physiology
- Criminal Law
- Criminology
- Biology
- Laboratory Skills
- Chemistry
- Mathematics
- Communications
- Work Experience
Components subject to change
- Entry Requirements
-
One of the following:
- Leaving Certificate or its equivalent with at least one science subject and minimum entry requirement Ordinary Level Maths. Extenuating circumstances may be considered
- Leaving Certificate Applied with a Distinction profile to include QQI Level 4 Biology
- Full QQI Level 4 Certificate with a Distinction profile and a science subject
- Mature Applicants – experience will be considered in lieu of formal qualifications
Applicants should have good basic literacy skills and mathematical skills.
- Career Opportunities
-
- Pharmaceutical research
- Laboratory Technicians
- Clinical trial monitoring
- Medical research
- Chemical Engineering
- Biochemical Engineering
- Biotechnology
- Forensic Science
- Higher Education Progression*
-
UCD University College Dublin:
- Science (DN200)
- Forestry (DN271)
- Food Science (DN261)
TUD Technological University Dublin (Grangegorman Campus):
- Science (DT271)
- Bio-Science (DT259)
- Analytical Chemistry (TU851)
TCD Trinity College Dublin:
- Physical Sciences (TR063)
UCC University College Cork:
- Chemistry with Forensic Science (CK402)
- Criminology (CK113)
TUD Technological University Dublin (Tallaght Campus):
- DNA and Forensic Analysis (TA326)
Please note that the courses listed above are only a select few, many other courses can be entered using this QQI award, please visit www.careersportal.ie for more.
- Course Co-Ordinator
-
Leah Dunne
- Where are they now?
-
Student: Aura Naceviciute - Forensics
 I chose this course because I was always interested and fascinated by the science behind forensic science and science in general. The forensic science course in BIFE has provided me with more than enough opportunities in showing me what forensic science is about, the modules within the course are broad ranged and very interesting. I never would have known if I liked criminology and criminal law but thanks to this course my curiosity and love for forensic science keeps growing. All of the teachers are kind and very helpful. The atmosphere around the college is really positive and friendly and everyone is kind to each other. I hope to use my results from this course in BIFE to go on to study Forensic Science in University College Cork.
I chose this course because I was always interested and fascinated by the science behind forensic science and science in general. The forensic science course in BIFE has provided me with more than enough opportunities in showing me what forensic science is about, the modules within the course are broad ranged and very interesting. I never would have known if I liked criminology and criminal law but thanks to this course my curiosity and love for forensic science keeps growing. All of the teachers are kind and very helpful. The atmosphere around the college is really positive and friendly and everyone is kind to each other. I hope to use my results from this course in BIFE to go on to study Forensic Science in University College Cork.